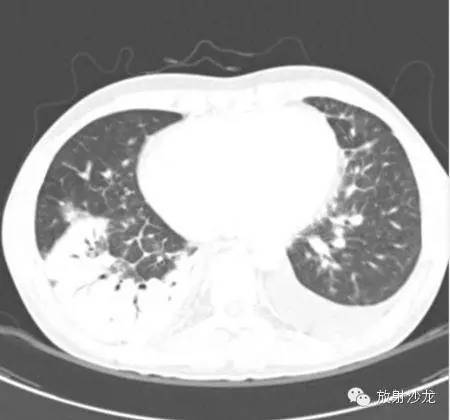
【病例】急性纤维素性机化性肺炎1例CT影像表现

【病例介绍】
男,29岁,一月前开始咳嗽咳痰,呼吸困难。患者既往有接受过腹膜透析治疗其晚期肾病病史。
第一次胸片:

第一次CT:


两周后CT:

高剂量类固醇治疗三周后:


(第一次胸片示两肺中野及右肺下野多发斑片状高密度影。胸部CT示多发斑片状磨玻璃样密度增高影以及实变影,同时伴有小叶间隔的增厚。其中有些病灶部分表现为“铺路石征”。两周后CT随访显示这些病灶的密度和范围都增大。电视辅助胸腔镜肺活检下,活检标本病理诊断结果为急性纤维素性机化性肺炎。上述病变经高剂量糖皮质激素治疗三周后明显改善。)
PS:铺路石征(Crazy-paving appearance):系磨玻璃影的背景下同时伴有网格状或细网格状小叶间隔和小叶内间隔增厚。
【讨论】
急性纤维素性机化性肺炎是近年来大量研究提出的新概念,其组织学以形成气腔内纤维素球为主要特征, 并存在于多种肺损伤中, 很容易与其他肺部疾病混淆。临床中急性纤维素性机化性肺炎属于一种急性肺损伤现象,病理研究显示急性纤维素性机化性肺炎的主要临床特点是有肺泡腔内纤维素等沉积,还有机化的疏松结缔组织,不存在弥漫性肺泡损伤,通过对典型肺泡进行研究, 显示其肺泡内有透明膜形成,没有较明显的嗜酸细胞浸润,且没有形成肉芽肿。
【临床、 影像及病理改变】
临床
通过对急性纤维素性机化性肺炎患者发病年龄进行调查, 显示急性纤维素性机化性肺炎的发病年龄跨度较大,婴儿、老年人均可能患有急性纤维素性机化性肺炎。急性纤维素性机化性肺炎的临床表现主要为呼吸困难、胸闷、气短等呼吸系统症状, 很多患者起病较急。在急性纤维素性机化性肺炎的临床治疗过程中, 由于部分患者对类固醇及免疫抑制剂反应良好, 至今尚未形成统一的临床治疗方案。对于急性患者而言, 其会很快发展成为呼吸衰竭, 具有较高的病死率, 因而需要对这类患者进行机械通气治疗, 对于亚急性患者,其病程较长。
【影像】
大量急性纤维素性机化性肺炎的影像学显示已经累及双肺,并存在弥漫浸润性病变,双肺还表现出弥漫斑片状实变阴影改变,一般双侧肺底比较多见,部分患者出现单侧结节状实变阴影, 很容易将其与结核、肿瘤等混淆。急性纤维素性机化性肺炎组织学特征主要是肺泡腔内沉积大量纤维素,同时形成均质嗜酸性的纤维素球,少数患者的纤维球周边出现新的纤维组织。
急性纤维素性机化性肺炎的临床诊断
大量研究强调在急性纤维素性机化性肺炎临床诊断过程中,大块活检肺部组织和纤维球非常重要, 但当前临床中仍然缺乏 AFOP 的标本代表性取材和组织形态的量化标准、还有报道显示 AFOP 的诊断尚未达到共识。另外, 相对于支气管镜活检和肺穿刺活检而言, 开胸肺活检的创伤及风险较大, 一般临床病理诊断以肺活检组织为主, 但对 AFOP 的临床诊断具有一定的局限性。
【参考文献】
[1]李娜,姬明丽. 急性纤维素性机化性肺炎五例临床和影像学及病理分析[J]. 临床医学,2015,10:37-38.
纵隔大细胞神经内分泌癌1例CT影像
张力性纵隔气肿影像表现及严重度分级
迅速增大的肺部结节,首先考虑良性,确诊需要肺穿
肺隔离症:易误诊为肺癌的占位性病变,肺穿刺禁忌!
肺段与肺内管道应用解剖
肺转移瘤的十种不典型CT表现
肺内淋巴结的CT表现特点及与病理对照
肺实变与肺不张的CT鉴别诊断
医生现身说法,这五种忙帮不得!
北大教授:要真正让医务人员有阳光体面的收入!医
为值夜班的医生护士鼓与呼:请给我们更多关注!
广东拟取消医院用药数量限制,满足患者多样性需求
博士、硕士入职就给精装房!又有医院不惜下血本招
历时7年之久,温医生宣判无罪!
重磅!四川发文:严禁限制医生多点执业
与真人医生诊断一致性达96%:AI医生应用前景广阔